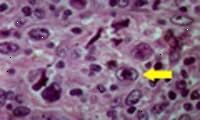
Κυττάρων Reed-Sternberg Κυττάρων Reed-Sternberg

Η παθοφυσιολογία της νόσου είναι μια περιγραφή του πώς μεγαλώνει και κινείται μέσω του σώματος. Η νόσος του Hodgkin έχει έναν ιδιαίτερο τρόπο εξάπλωσης.
Η νόσος του Hodgkin είναι διαφορετικό από άλλα λεμφώματα, εξαιτίας της παρουσίας ενός ειδικού κυττάρου, το κύτταρο Reed-Sternberg. Στις περισσότερες λεμφώματα, τα καρκινικά κύτταρα αποτελούν το μεγαλύτερο μέρος ενός όγκου. Στη νόσο του Hodgkin, τα κύτταρα Reed-Sternberg αποτελούν μόνο ένα μικρό μέρος των κυττάρων σε ένα καρκινικό λεμφαδένα. Το υπόλοιπο των κυττάρων είναι φυσιολογικό.
Οι επιστήμονες τώρα στο συμπέρασμα ότι η νόσος του Hodgkin, δεν είναι μια ενιαία ασθένεια με διαφορετικούς τύπους. Μάλλον, η νόσος του Hodgkin αντιπροσωπεύει μία ομάδα από τουλάχιστον δύο ασθενειών. Οι δύο κύριες ταξινομήσεις των HD είναι: ασθένεια "κλασικό" νόσος του Hodgkin (CHD) και λεμφοκυττάρων-κυρίαρχο του Hodgkin (LPHD).
Κάθε τύπος του όγκου της νόσου του Hodgkin μεγαλώνει σε ελαφρώς διαφορετικούς τρόπους.
Κλασική ασθένεια του Hodgkin:
Οζώδης σκλήρυνση (NS). Οζώδης Σκλήρυνση (NS) αντιπροσωπεύει το 60-80% όλων των περιπτώσεων της νόσου του Hodgkin. Είναι σχεδόν πάντα εμφανίζεται σε άτομα μεταξύ των ηλικιών 15 και 35, και είναι πολύ πιο συχνή στις γυναίκες παρά στους άνδρες. Οι περισσότεροι άνθρωποι με NS δεν έχουν αρχικά συμπτώματα. Όταν βρεθεί η ασθένεια, είναι συνήθως στο Στάδιο Ι ή II.
Λεμφοκυττάρων πλούσια (LR) ή λεμφικού πολλαπλασιαστικές (LP). Νόσο του Hodgkin LP βρίσκεται συνήθως σε άτομα στη δεκαετία του '30 και του '40 τους. Αντιπροσωπεύει περίπου το 5% του συνόλου των περιπτώσεων. Περισσότερο τους άνδρες από τις γυναίκες παίρνουν την ασθένεια LP του Hodgkin, και το ποσοστό θεραπείας είναι πολύ υψηλό. Β συμπτώματα είναι πολύ συχνή σε LP του Hodgkin.
Μικτή-κυτταροβρίθειας (MC). Μικτή-Κυτταρικότητα (MC) του Hodgkin μπορεί να βρεθεί σε όλες τις ηλικιακές ομάδες, αλλά είναι πιο συχνή σε άτομα στη δεκαετία του '30 και του '40 τους. Είναι πιο συχνή στους άνδρες, και οι περισσότεροι άνθρωποι δεν έχουν διαγνωστεί μέχρι η νόσος βρίσκεται σε στάδιο ΙΙΙ ή IV. Β συμπτώματα είναι πολύ συχνές, και συχνά να βοηθήσει ο γιατρός διαγνώσει την ασθένεια.
Λεμφοκυττάρων εξαντληθεί (LD). Λεμφοκυττάρων Εξαντλημένο (LD) η νόσος του Hodgkin είναι η νόσος του πιο επιθετική Hodgkin. Αυτή η υπο-είδος είναι πολύ σπάνιο, που αντιπροσωπεύουν μόνο το 1% των περιπτώσεων της νόσου του Hodgkin. Περισσότερα κύτταρα Reed-Sternberg είναι παρόντες στους λεμφαδένες κάποιον με νόσο του Hodgkin LD από ό, τι σε οποιοδήποτε άλλο τύπο. Υπάρχουν δύο τύποι της νόσου του Hodgkin LD: δικτυωτό και διάχυτη ίνωση. Οι άνθρωποι με δικτυωτό LD έχουν συνήθως κάποια εισβολή του καρκίνου του μυελού των οστών τους. Ίδιοι, και σε περιβάλλοντα ιστό του σώματος εκείνους με διάχυτη ίνωση έχουν συνήθως περισσότερο καρκίνου σε λεμφαδένες. Νόσο του Hodgkin LD είναι πιο συχνή σε ηλικιωμένους άνδρες. Οι περισσότεροι άνθρωποι με αυτή τη μορφή της νόσου του Hodgkin διαγιγνώσκεται σε προχωρημένο στάδιο.
Νόσος Οζώδης λεμφοκυττάρων κυρίαρχο Hodgkin λέμφωμα (NLPHD), αποτελεί περίπου το 5% όλων των περιπτώσεων της νόσου του Hodgkin. Είναι τρεις φορές πιο συχνή στους άνδρες παρά στις γυναίκες, και επηρεάζει συνήθως τους νέους ενηλίκους μεταξύ τους '30-'50. Οι περισσότεροι ασθενείς που διαγιγνώσκονται σε πρώιμο στάδιο και η πλειοψηφία ανταποκριθεί σε θεραπεία με μια πλήρη ανταπόκριση. Κλασικό κύτταρα Reed-Sternberg δεν έχουν δει ή είναι πολύ ασυνήθιστο σε δείγματα ασθενών ιστών. Αντ 'αυτού, μεγάλο, κυκλικό MeshWorks κυττάρων αναλάβει λεμφαδένες. Αργά υποτροπές είναι συχνές, αλλά συνήθως δεν επηρεάζουν την επιβίωση. Το ποσοστό επιβίωσης είναι ευνοϊκές ακόμα και στους ασθενείς με υποτροπή της νόσου.
